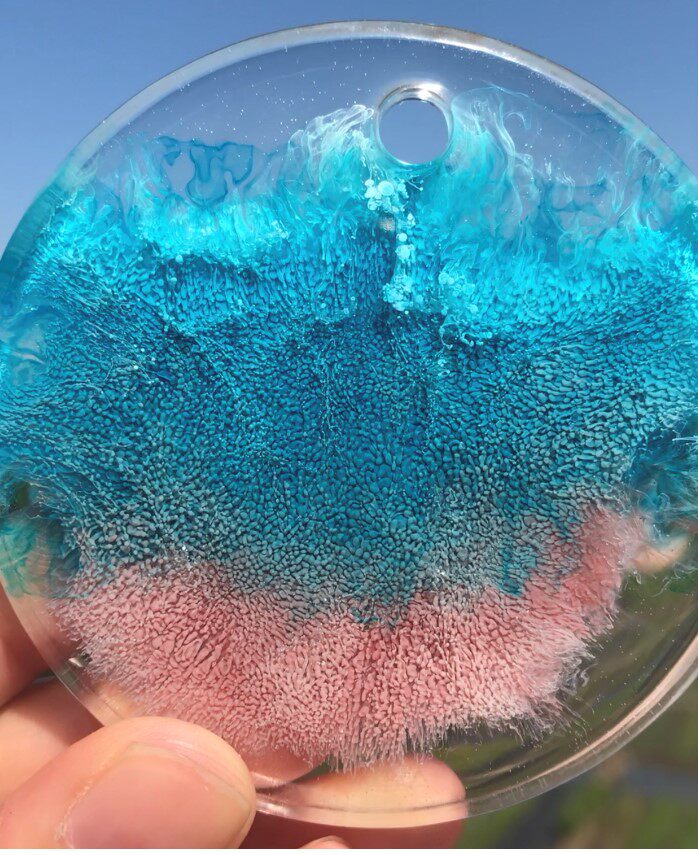

- Таобао
- Строительные материалы
- Краски
- Краски аксессуары
- Вставить
- 577002314061
Артрезиновая облачная смоля арт чернил капли чернил 3D эффект спасения

Цена: 208-2 452руб. (¥9.8)
Артикул: 577002314061
Доставка по Китаю (НЕ включена в цену):
212 руб. (¥10)
Вес товара: ~0.7 кг. Указан усредненный вес, который может отличаться от фактического. Не включен в цену, оплачивается при получении.
Описание товараPHA+PGltZyBzcmM9Imh0dHBzOi8vaW1nLmFsaWNkbi5jb20vaW1nZXh0cmEvaTQvMzI5OTUzMjMyNC9PMUNOMDExVDJRdVgwNVFrWWJXR3ZfISEzMjk5NTMyMzI0LmpwZyI+M0QgSGFsbywg0L/RgNC+0YHRgtCw0Y8g0Lgg0LLRi9GB0L7QutC+INGB0LrQvtC90YbQtdC90YLRgNC40YDQvtCy0LDQvdC90LDRjyDQvtC/0LXRgNCw0YbQuNGPLCDQsCDQvdC1INC30LDRgtGD0YXQsNC90LjQtSDQvNC+0LPRg9GCINCx0YvRgtGMINC/0L7QtNGF0L7QtNGP0YnQuNC80Lgg0LTQu9GPINC60LDRgNGC0LjQvSDRgdC80L7Qu9GLLCDRgNCw0LfQu9C40YfQvdGL0YUg0YLQuNC/0L7QsiDRg9C60YDQsNGI0LXQvdC40Lkg0LbQuNC00LrQvtGB0YLQuCDQuCDRgdC+0LfQtNCw0L3QuNGPINC40YHQutGD0YHRgdGC0LLQsCDRg9C70YPRh9GI0LXQvdC40Y8g0LTQvtC80LAuINCU0LvRjyDQv9C+0LvRg9GH0LXQvdC40Y8g0LHQvtC70YzRiNC10LPQviDQv9GA0L7RhtC10YHRgdCwINC/0YDQvtC40LfQstC+0LTRgdGC0LLQsCDRgdC8LiDQkiDQstC40LTQtdC+LjxpbWcgc3JjPSJodHRwczovL2ltZy5hbGljZG4uY29tL2ltZ2V4dHJhL2kyLzMyOTk1MzIzMjQvTzFDTjAxMVQyUXVmaWNuMlkwdkNKXyEhMzI5OTUzMjMyNC5qcGciPjxpbWcgc3JjPSJodHRwczovL2ltZy5hbGljZG4uY29tL2ltZ2V4dHJhL2kzLzMyOTk1MzIzMjQvTzFDTjAxd1ZYdHA1MVQyUXZjVENRUnNfISEzMjk5NTMyMzI0LmpwZyI+PGltZyBzcmM9Imh0dHBzOi8vaW1nLmFsaWNkbi5jb20vaW1nZXh0cmEvaTIvMzI5OTUzMjMyNC9PMUNOMDExVDJRdmViY210RnR5TUpfISEzMjk5NTMyMzI0LmpwZyI+PGltZyBzcmM9Imh0dHBzOi8vaW1nLmFsaWNkbi5jb20vaW1nZXh0cmEvaTEvMzI5OTUzMjMyNC9PMUNOMDExVDJRdmRUaUlnVTdwQXpfISEzMjk5NTMyMzI0LmpwZyI+PGltZyBzcmM9Imh0dHBzOi8vaW1nLmFsaWNkbi5jb20vaW1nZXh0cmEvaTMvMzI5OTUzMjMyNC9PMUNOMDExVDJRdmNUYTdtSUhOd0JfISEzMjk5NTMyMzI0LmpwZyI+PGltZyBzcmM9Imh0dHBzOi8vaW1nLmFsaWNkbi5jb20vaW1nZXh0cmEvaTEvMzI5OTUzMjMyNC9PMUNOMDExVDJRdmZCekViWnlidlhfISEzMjk5NTMyMzI0LmpwZyI+M0QgU2FsbW9uaWMgQXJ0IEluayBOZXdseSBQdXNoIDQgQ3J5c3RhbCBDb2xvcnMgKENyeXN0YWwgQmx1ZSwg0LrRgNC40YHRgtCw0LvRjNC90L4g0LfQtdC70LXQvdGL0LksINC60YDQuNGB0YLQsNC70LvQuNGH0LXRgdC60LjQuSDQv9C+0YDQvtGI0L7Quiwg0LrRgNC40YHRgtCw0LvRjNC90L4g0L/Rg9GA0L/Rg9GA0L3Ri9C5KSDQndC+0LLQsNGPINC/0YDQvtC30YDQsNGH0L3QsNGPINGB0LjRgdGC0LXQvNCwINC60YDQuNGB0YLQsNC70LvQuNGH0LXRgdC60L7Qs9C+INGG0LLQtdGC0LAg0L/RgNC+0LTQvtC70LbQsNC10YIg0LfQsNC/0YPRgdC60LDRgtGMJmFtcDtoZWxsaXA7JmFtcDtoZWxsaXA7PGltZyBzcmM9Imh0dHBzOi8vaW1nLmFsaWNkbi5jb20vaW1nZXh0cmEvaTMvMzI5OTUzMjMyNC9PMUNOMDExVDJRdk1WV1N0SlN5Rk5fISEzMjk5NTMyMzI0LmpwZyI+PGltZyBzcmM9Imh0dHBzOi8vaW1nLmFsaWNkbi5jb20vaW1nZXh0cmEvaTQvMzI5OTUzMjMyNC9PMUNOMDExVDJRdkZRallBSzVlMmhfISEzMjk5NTMyMzI0LmpwZyI+PGltZyBzcmM9Imh0dHBzOi8vaW1nLmFsaWNkbi5jb20vaW1nZXh0cmEvaTEvMzI5OTUzMjMyNC9PMUNOMDExVDJRdkxjejlPeXFaOUNfISEzMjk5NTMyMzI0LmpwZyI+PGltZyBzcmM9Imh0dHBzOi8vaW1nLmFsaWNkbi5jb20vaW1nZXh0cmEvaTEvMzI5OTUzMjMyNC9PMUNOMDExVDJRdkZRa1VYbENtdHNfISEzMjk5NTMyMzI0LmpwZyI+PGltZyBzcmM9Imh0dHBzOi8vaW1nLmFsaWNkbi5jb20vaW1nZXh0cmEvaTMvMzI5OTUzMjMyNC9PMUNOMDExVDJRdkxPY2MxTGxzVHpfISEzMjk5NTMyMzI0LmpwZyI+PGltZyBzcmM9Imh0dHBzOi8vaW1nLmFsaWNkbi5jb20vaW1nZXh0cmEvaTIvMzI5OTUzMjMyNC9PMUNOMDExVDJRdktibU1tVWtkbmZfISEzMjk5NTMyMzI0LmpwZyI+PGltZyBzcmM9Imh0dHBzOi8vaW1nLmFsaWNkbi5jb20vaW1nZXh0cmEvaTQvMzI5OTUzMjMyNC9PMUNOMDExVDJRdkxoalRUOUJ5NzBfISEzMjk5NTMyMzI0LmpwZyI+PGltZyBzcmM9Imh0dHBzOi8vaW1nLmFsaWNkbi5jb20vaW1nZXh0cmEvaTQvMzI5OTUzMjMyNC9PMUNOMDExVDJRdkxPZGNQZmFUY1pfISEzMjk5NTMyMzI0LmpwZyI+PGltZyBzcmM9Imh0dHBzOi8vaW1nLmFsaWNkbi5jb20vaW1nZXh0cmEvaTIvMzI5OTUzMjMyNC9PMUNOMDExVDJRdktCSjd6dzN1RlRfISEzMjk5NTMyMzI0LmpwZyI+PGltZyBzcmM9Imh0dHBzOi8vaW1nLmFsaWNkbi5jb20vaW1nZXh0cmEvaTQvMzI5OTUzMjMyNC9PMUNOMDExVDJRdlR4TzlYREs0dzZfISEzMjk5NTMyMzI0LmpwZyI+PGltZyBzcmM9Imh0dHBzOi8vaW1nLmFsaWNkbi5jb20vaW1nZXh0cmEvaTEvMzI5OTUzMjMyNC9PMUNOMDExVDJRdlVZbHE1a1dnVmlfISEzMjk5NTMyMzI0LmpwZyI+PC9wPg==
Продавец:广州道泽
Рейтинг:

Всего отзывов:0
Положительных:0
Выберите вариацию / цвет

- 10 мл

- 10 мл
- 10 мл
- 10 мл
- 10 мл

- 10 мл


- Sanlianyuan плесень
- Базовый комплект, 12 цветов


- 10 мл

- 10 мл


- 10 мл
- Тиффани Блю (10 мл)

Добавить в корзину
- Информация о товаре
- Фотографии
| Цвет: | 10 мл, Зеленый, 10 мл, Sanlianyuan плесень, 10 мл, Оранжевый, 10 мл, 10 мл, 10 мл, 10 мл, 10 мл, 10 мл, 10 мл, 10 мл, 10 мл, Белый, 10 мл, Базовый комплект, 12 цветов, 10 мл, Сиреневый, 10 мл, Тиффани Блю (10 мл), 10 мл, 10 мл, 10 мл, Черный, 10 мл, 10 мл |
 3D Halo, простая и высоко сконцентрированная операция, а не затухание могут быть подходящими для картин смолы, различных типов украшений жидкости и создания искусства улучшения дома. Для получения большего процесса производства см. В видео.
3D Halo, простая и высоко сконцентрированная операция, а не затухание могут быть подходящими для картин смолы, различных типов украшений жидкости и создания искусства улучшения дома. Для получения большего процесса производства см. В видео.

3D Salmonic Art Ink Newly Push 4 Crystal Colors (Crystal Blue, кристально зеленый, кристаллический порошок, кристально пурпурный) Новая прозрачная система кристаллического цвета продолжает запускать……
3D Salmonic Art Ink Newly Push 4 Crystal Colors (Crystal Blue, кристально зеленый, кристаллический порошок, кристально пурпурный) Новая прозрачная система кристаллического цвета продолжает запускать……




















